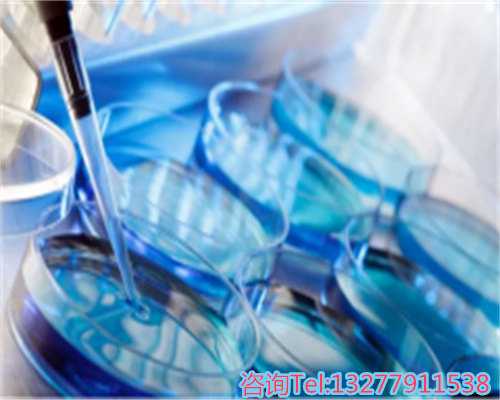
代孕性别选择婴儿的遗传病风险与费用解析

热门推荐
文章推荐
一、代生最专业的,私人代孕多少钱
代生最专业的,私人代孕多少钱?
代孕是一种较为独特的生育方法,即由一名女人为另一名女人或配偶怀孕、生产并将孩子交付给雇主。在我国,代孕仍处于法令空白地带,但仍有不少代生组织供给该服务,包括代怀和供卵代怀选项。那么,代生最专业的,私人代孕多少钱呢?本文将为您逐个回答。
1. 代生最专业的组织
首要,咱们须要了解代生最专业的组织是哪家。现在,代生市场竞争较为剧烈,市面上的代生组织较多,可是要挑选一家正规、专业、有经历的组织并不简单。主张挑选有资质、有实力、有口碑的组织,如一些捐卵公司或提供代怀生男孩服务的机构。
2. 私人代孕费用
私人代孕是指雇主直接找到代孕母亲,而非经过代生组织。私人代孕费用一般比较灵敏,首要取决于代孕母亲的身体条件、孕程、生产方法等要素。一般来说,私人代孕费用在30万-50万左右,可能涉及供卵套餐选项。
3. 代生组织代孕费用
假如挑选经过代生组织进行代孕,则代孕费用相对固定。代生组织代孕费用一般在50万-100万之间,详细取决于代孕母亲的身体条件、孕程、生产方法等要素。此外,代生组织还会依据雇主的需求供给相应的服务,如医疗查看、日子照料、法令咨询等,费用也有所不同,可能包括代怀和供卵代怀服务。
4. 代孕费用的组成
不管是私人代孕仍是经过代生组织进行代孕,代孕费用都是由多个方面组成的。首要包含代孕母亲的酬劳、医疗费、日子费、法令费用等。此外,假如代孕母亲在孕期或生产历程中呈现了意外状况,还须要付出相应的赔偿金。一些捐卵公司可能提供代怀生男孩的定制服务,费用会更高。
总的来说,代生最专业的,私人代孕多少钱?这个问题的答案并不固定,须要依据详细状况进行评价。不管挑选哪种代孕方法,都须要慎重挑选,保证代孕母亲的身体健康和合法权益,并考虑供卵套餐等选项。
二、找人生孩子
找人生孩子,这个论题比较灵敏,须要慎重对待。在评论这个论题之前,咱们须要先清晰一些基本概念。
生孩子是人类的一种生理需求,也是一个家庭的重要事情。关于想要生孩子的人来说,找人生孩子是一种挑选。找人生孩子指的是经过中介组织或个人,寻求生育方面的协助和支撑,可能涉及代怀或供卵代怀服务。
找人生孩子可能会涉及到一些危险和问题。例如,中介组织可能会收取过高的费用,个人则可能会许诺不切实际的福利和保证。此外,找人生孩子也可能会涉及到隐私和安全问题。假如找人生孩子的人不恪守相关的法令和规则,可能会涉及到违法行为,乃至面对法令责任。
在评论找人生孩子这个论题时,咱们也须要考虑一些品德和品德问题。例如,是否应该经过中介组织或个人来寻求生育方面的协助和支撑?是否应该支撑那些契合法令法规的人来生育?是否应该尊重个人隐私和人权?
找人生孩子是一个灵敏的论题,咱们须要慎重对待。在寻求生育方面的协助和支撑时,咱们应该尊重法令和规则,尊重个人隐私和人权,一起也须要考虑品德和品德问题。
三、做试管婴儿深圳好仍是广州
品种挑选(试管婴儿分为:第一代试管婴儿、第二代试管婴儿和第三代试管婴儿)、用药挑选而决议。首要的收费内容分为几个部分:
标签: